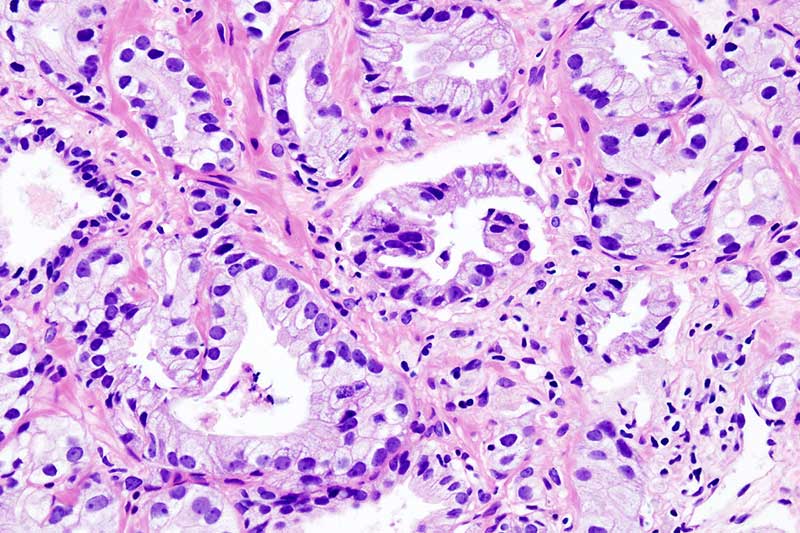

بایگانی برچسب ها: ورق شیروانی
چگونه سازندگان و تولیدکنندگان نهایی می توانند کار را به سرعت تمام کنند (بخش 2)
اما در مورد روکش کننده پودری سفارشی چطور؟
روکش تغییر سریع
راجر تالبرت می تواند درد یک خدمات دهنده سفارشی را احساس کند. مدیر اجرای...
چگونه سازندگان و تولیدکنندگان نهایی می توانند کار را به سرعت تمام کنند (بخش 1)
سازندگان و تولیدکنندگان نهایی می توانند با هم کار کنند تا زمان کار را کاهش دهند. سازندگان ورق های فلزی و رنگ های سفارشی - برخلاف بعضی م...
پروسه رنگ الکترواستاتیک (بخش 3)
پخت قطعات رنگ پودری شده
مواد پودر ترموست به مقدار مشخصی، از انرژی حرارتی برای مدت زمان مشخصی، برای تولید واکنش شیمیایی مورد نیاز برا...
پروسه رنگ الکترواستاتیک (بخش 2)
کاربرد پودر
متداول ترین روش برای استفاده از مواد رنگ دهنده پودری، استفاده از دستگاه اسپری با سیستم تحویل پودر و تفنگ اسپری الکترواست...
پروسه رنگ الکترواستاتیک (بخش 1)
رنگ الکترواستاتیک یکی از با دوام ترین لایه های نهایی است که می توان آن را برای محصولات تولیدی صنعتی به کار برد و به دلیل کم بودن ترکیبا...
نوار حامل و سیستم های رنگ (E-coat)
انتخاب سیستم نوار حامل مناسب، فناوری روکش و تجهیزات جانبی.
انتخاب سیستم رنگ آمیزی یا پودر بستگی به عوامل مختلفی، از جمله انواع ق...
رنگ پودری و ساختمان سبز
چگونه رنگ پودری می تواند به کاربردهای معماری (ساختاری) در دستیابی به گواهینامه های زیست محیطی کمک کند.
صنعت معماری، هنگامی که صح...
چرا بیشتر مدارس و دانشگاه ها رنگ های میکروب کش را ترجیح می دهند
از نقاشی غار های ماقبل تاریخ و نقاشی های دیواری مثل سقف کلیسای سیستین گرفته تا پالت های رنگی ای که امروزه، فضاهای مدرن داخلی ما را تغیی...
آیا رنگ های صنعتی می توانند سازگار با محیط زیست باشند
همانند اکثر صنایع، فضاهای رنگ آمیزی صنعتی، تحت تاثیر علاقه مندی مدرنیته به سازگار بودن با محیط زیست قرار گرفته است. طراحی، ساخت و ارتقا...
مزایای رنگ پودری در نقاشی صنعتی
رنگ پودری یک فرایند جذاب است که مزایای بی شماری را برای سطح های نیازمند رنگ فراهم می کند. در کاربرد های نقاشی صنعتی، از رنگ پودری به طو...